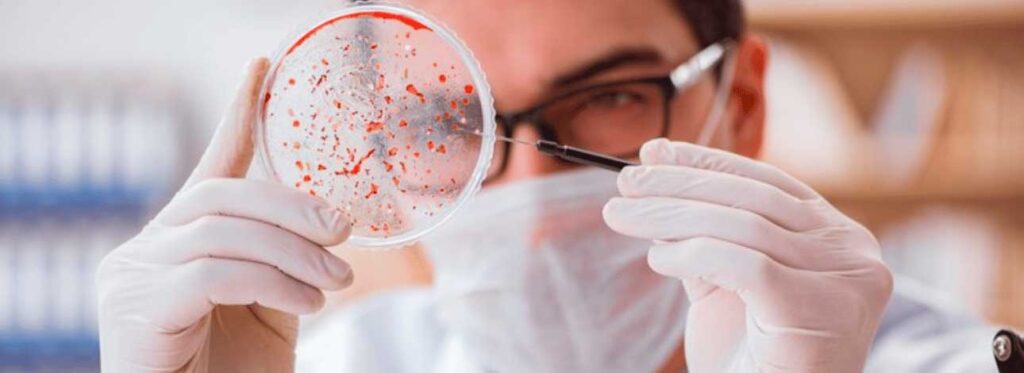
spx-clinica-spx-imagem-importancia-do-exame-parasitologico

Importância do Exame Parasitológico: Tudo sobre o Procedimento
Saiba mais sobre a importância do exame parasitológico e quais são seus benefícios para a saúde com o diagnóstico precoce de infecções
Antecipadamente, a importância do exame parasitológico na área da saúde reside na capacidade de detecção e monitoramento de infecções parasitárias, abrangendo, assim, uma variedade de métodos laboratoriais projetados para identificar a presença de parasitas no organismo humano.
Em suma, tais parasitas podem variar de protozoários a helmintos, e têm o potencial para causar uma série de doenças, muitas das quais assintomáticas inicialmente, tornando o exame parasitológico um procedimento crucial para a prevenção e controle dessas infecções.
Além disso, o exame parasitológico assume um papel crucial em situações clínicas diversas, bem como a investigação de sintomas gastrointestinais inexplicados, febres prolongadas, e na triagem de populações em risco.
Qual a Importância do Exame Parasitológico?

O exame parasitológico, então, é um procedimento de extrema importância no campo da medicina, permitindo a detecção e identificação de parasitas que podem comprometer a saúde humana. Ao analisar amostras biológicas, como fezes, urina ou sangue, os médicos podem identificar a presença desses organismos, o que é crucial para diagnosticar e tratar uma variedade de doenças parasitárias.
A precisão do exame é particularmente relevante em regiões onde as infecções parasitárias são endêmicas. A detecção precoce é fundamental para evitar complicações mais graves, promovendo a intervenção terapêutica antes que a infecção se agrave. Além disso, há a monitorização de tratamentos, permitindo avaliar a eficácia das terapias administradas.
Ainda assim, esse procedimento também contribui significativamente para a saúde pública, facilitando a identificação de surtos de doenças parasitárias e direcionando medidas preventivas em comunidades em risco. A informação obtida por meio do exame parasitológico é, assim, indispensável na promoção da saúde e no controle eficaz de infecções parasitárias.
Quando Realizar?
A realização do exame parasitológico é determinada por diversos fatores, sendo guiada principalmente pelos sintomas apresentados pelo paciente e pelo histórico epidemiológico da região. Logo, é indicado quando há a suspeita de infecções parasitárias devido a sintomas específicos, por exemplo:
- Diarreia Persistente;
- Dor Abdominal;
- Perda de Peso Inexplicada;
- Febre Prolongada;
- Sangue nas Fezes.
Analogamente, especialistas podem recomendar a realização periódica do exame em populações de risco, como viajantes que visitam regiões com alta prevalência de parasitas específicos. Em situações de surtos ou epidemias, a triagem em larga escala também pode ser adotada para identificar casos assintomáticos e controlar a disseminação da infecção.
Sobre a Solicitação do Exame
Em síntese, o exame parasitológico pode ser solicitado por diferentes tipos de médicos, dependendo do contexto clínico e dos sintomas apresentados pelo paciente. Geralmente, especialistas em Infectologia, Gastroenterologia, Clínica Médica e Pediatria estão entre os que podem solicitar e interpretar resultados.
Além disso, em situações de infecções parasitárias que afetam sistemas específicos, como o sistema nervoso, pode ser necessário o envolvimento de um Neurologista. Em muitos casos, o clínico geral pode ser o primeiro médico a ser consultado, e ele encaminhará o paciente para um especialista, conforme a necessidade.
Os Cuidados Necessários na Realização do Exame

A realização do exame parasitológico demanda cuidados específicos para assegurar a precisão e confiabilidade dos resultados. De maneira idêntica, os médicos devem aderir estritamente aos protocolos estabelecidos, e os pacientes precisam seguir as instruções fornecidas para garantir a eficácia do exame parasitológico.
Essa abordagem cuidadosa não apenas assegura resultados mais precisos, mas também contribui para a eficácia global do processo diagnóstico e, consequentemente, para o tratamento adequado.
Cuidados Pré-Exame do Paciente
Coleta de Amostras Adequada: O paciente deve seguir rigorosamente as instruções fornecidas para garantir uma coleta de amostras adequada. Isso pode incluir a utilização de recipientes específicos, a quantidade necessária de material biológico e a atenção para evitar contaminações externas durante o processo.
Higiene Pessoal: Manter uma boa higiene pessoal é crucial para evitar contaminações das amostras e garantir resultados precisos, além de seguir orientações específicas de higiene para evitar contaminação da urina, fezes ou sangue .
Informações Médicas: O paciente deve fornecer informações ao médico, incluindo histórico de sintomas, medicamentos em uso e condições médicas preexistentes.
Jejum, se necessário: Em alguns casos, como exames de sangue, o paciente pode ser orientado a realizar o exame em jejum para garantir resultados precisos.
Comunicação com o Médico: Acima de tudo, qualquer dúvida ou preocupação relacionada ao exame deve ser prontamente comunicada ao especialista responsável.
Cuidados Pós-Exame
Acompanhamento Médico: Após a realização do exame parasitológico, é essencial que o paciente siga as orientações do médico e retorne para o acompanhamento médico.
Seguir as Recomendações Pós-Coleta: Dependendo do tipo de exame, podem existir recomendações específicas para o período pós-coleta. Isso pode incluir restrições alimentares temporárias, interrupção de certos medicamentos ou atividades físicas.
Monitorar Sintomas: Caso o exame tenha sido realizado devido a sintomas específicos, é importante que o paciente continue a monitorar qualquer mudança ou persistência desses sintomas após o procedimento.
Manuseio Adequado dos Resultados: Deve-se receber orientações claras sobre como acessar e interpretar os resultados do exame. Em caso de dúvidas ou preocupações, é fundamental entrar em contato com o especialista responsável para obter esclarecimentos.
Exames de Análises Clínicas em Evidência

Os exames de análises clínicas compreendem uma ampla variedade de testes laboratoriais realizados em amostras biológicas, como sangue, urina, fezes, entre outras, com o objetivo de obter informações sobre o estado de saúde de um paciente. O exame parasitológico, que inclui a análise de amostras de fezes, urina ou sangue para identificação de parasitas, é uma parte essencial desse conjunto de exames.
Os principais exames de análises clínicas abrangem:
Hemograma: Avalia os componentes do sangue, incluindo glóbulos vermelhos, glóbulos brancos e plaquetas, fornecendo informações sobre a saúde do sistema circulatório.
Glicemia: Mede os níveis de glicose no sangue, sendo fundamental para o diagnóstico e monitoramento do diabetes.
Perfil Lipídico: Avalia os níveis de colesterol total, colesterol LDL, colesterol HDL e triglicerídeos, oferecendo informações sobre o perfil lipídico e o risco cardiovascular.
Teste de Função Hepática: Inclui exames como ALT, AST, bilirrubina, entre outros, para avaliar a saúde do fígado.
Teste de Função Renal: Mede a creatinina e a ureia, fornecendo informações sobre a função dos rins.
Exame Parasitológico de Fezes: Identifica a presença de parasitas no sistema gastrointestinal, auxiliando no diagnóstico de infecções parasitárias.
Uroanálise: Avalia a composição da urina, detectando possíveis problemas renais, infecciosos ou metabólicos.
Agende Sua Consulta e Seus Exames na SPX Clínica!
Em conclusão, a importância do exame parasitológico emerge na detecção precoce e tratamento eficaz de infecções parasitárias, contribuindo para a preservação da saúde individual e coletiva. Além disso, a consulta com médicos especialistas, como Clínicos Gerais e Gastroenterologistas, é essencial para uma abordagem integral.
Para isso, a SPX Clínica Santana de Parnaíba (consulta e exames), e a SPX Joinville e SPX Taubaté (somente exames de imagens) fornecem o apoio necessário no cuidado do seu corpo e do seu organismo.
Faça Seu Agendamento ainda hoje clicando aqui!